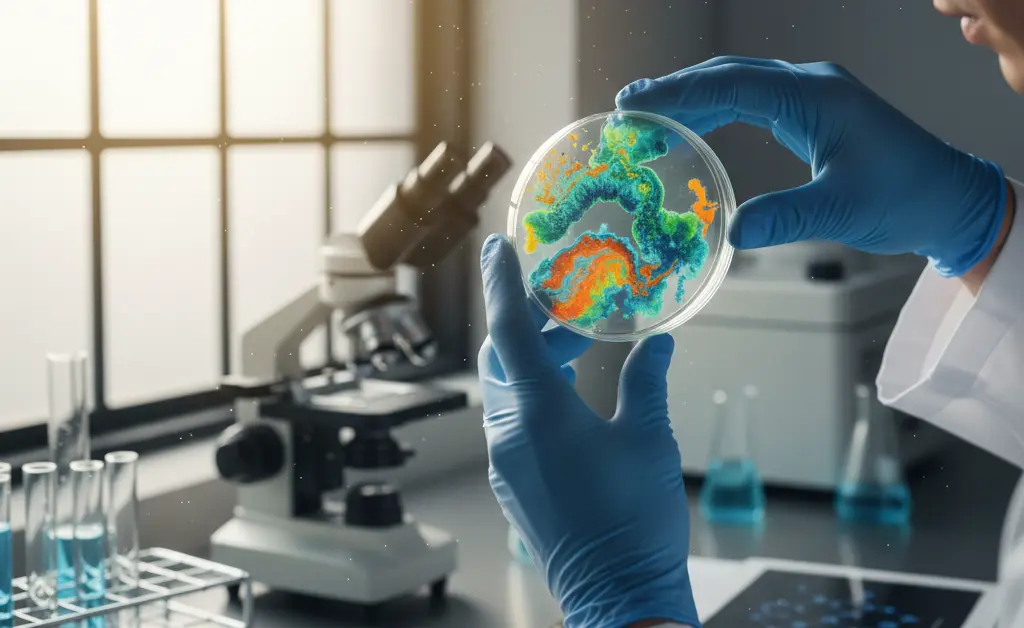
A focused laboratory scene illustrating advancements in turkey tail mushroom research studies with researchers examining samples.

For centuries, certain natural remedies were primarily understood through anecdotal accounts and traditional practices. Over time, however, a growing body of scientific inquiry has begun to illuminate the specific mechanisms and potential benefits behind these historical observations. This shift from mere tradition to evidence-backed understanding marks a significant evolution in our approach to natural health. Recent turkey tail mushroom research studies exemplify this progression, moving beyond historical lore to systematically investigate the fungus’s bioactive compounds and their influence on human health. Through rigorous experimentation and clinical trials, the scientific community is progressively refining our comprehension of how these unique fungi interact with biological systems, offering clearer insights into their therapeutic potential and immunological effects.
Overview of Turkey Tail Mushroom Research Studies
The journey from traditional knowledge to modern scientific understanding has significantly shaped our perspective on natural substances. For the turkey tail mushroom (Trametes versicolor), also known as Coriolus versicolor, this transition is particularly evident in the growing number of scientific investigations. These comprehensive turkey tail mushroom research studies aim to decipher the complex interactions between its bioactive components and human physiology, moving beyond centuries of anecdotal evidence to establish an evidence-based framework.
Historical Context of Research and Traditional Use
Historically, various cultures around the world have revered turkey tail mushrooms for their perceived health-promoting properties. In traditional Chinese medicine (TCM) and Japanese herbal medicine, it has been a staple for centuries, often used for promoting general well-being and supporting vitality. Practitioners observed its effects on strengthening the body and believed it could help maintain balance. This deep-rooted traditional use provided the initial impetus for modern scientific inquiry, as researchers sought to validate these historical observations through contemporary scientific methods and rigorous experimentation.
Primary Areas of Scientific Focus
Contemporary scientific exploration of turkey tail mushrooms encompasses several key areas. A significant portion of research is dedicated to understanding its immunomodulatory effects, investigating how its compounds interact with and potentially influence the immune system. Another major focus includes exploring its potential antioxidant capabilities, which involve protecting cells from oxidative stress. Additionally, researchers are examining anti-inflammatory responses and the general therapeutic potential of various extracts. The ultimate goal is to identify specific mechanisms of action and the active compounds responsible for these observed effects, thereby providing a clear, scientific basis for its traditional applications.
Research into Therapeutic Effects of Turkey Tail Mushrooms

The quest to understand the broader therapeutic landscape of this medicinal fungus forms a cornerstone of contemporary turkey tail mushroom research studies. Scientists are meticulously exploring its potential impact on various physiological processes, aiming to uncover its full spectrum of health properties.
Findings from In Vitro and Pre-clinical Studies
Initial investigations into the therapeutic effects of turkey tail mushrooms often begin with *in vitro* (cell culture) and pre-clinical (animal) studies. These foundational studies allow researchers to observe the mushroom’s compounds in controlled environments, providing early insights into potential mechanisms. Findings from these stages have suggested various effects, including antioxidant activities that may help combat cellular damage, and anti-inflammatory responses that could modulate inflammatory pathways. Some pre-clinical studies have also explored its influence on cellular proliferation and differentiation, laying the groundwork for more advanced human investigations. While promising, these early results serve primarily as indicators for further research.
Results from Clinical Trials and Human Studies
Moving from the laboratory to human subjects, clinical trials represent a critical phase in validating the therapeutic potential suggested by earlier research. Human studies on turkey tail mushrooms have often focused on immune support, especially in contexts where immune health is a primary concern. These trials typically involve administering specific turkey tail extracts or supplements to participants and monitoring various health markers. The results from these clinical trials and human studies contribute valuable scientific evidence, helping to delineate the specific conditions under which turkey tail may offer support and to understand its general tolerability and safety profile. Researchers carefully analyze the data to identify consistent patterns and confirm observed effects. Reputable institutions such as the NIH often support and conduct rigorous research in this area.
Scientific Investigations into Turkey Tail Mushroom’s Immune Effects

Among the most thoroughly investigated aspects of this mushroom are its profound immune effects. A significant portion of current turkey tail mushroom research studies is dedicated to unraveling the intricate ways in which its compounds interact with the immune system, often positioning it as a potent immune modulator.
Mechanisms of Nonspecific Immune Modulation
Turkey tail mushrooms are particularly noted for their potential role in nonspecific immune modulation. This means they are believed to influence the overall activity and balance of the immune system rather than targeting specific pathogens directly. Scientific investigations suggest that certain bioactive components, especially complex polysaccharides like beta-glucans, can interact with various immune cells. These interactions may lead to enhanced activity of immune cells such as macrophages, natural killer cells, and T-cells, which are crucial for the body’s natural defenses. The mushroom’s compounds are thought to support a balanced immune response, potentially bolstering the innate immune system and optimizing the communication between immune cells, thereby contributing to overall immune health.
Key Bioactive Compounds in Turkey Tail Mushroom Research
The distinctive properties observed in turkey tail mushroom research studies are largely attributed to a unique array of bioactive compounds. Scientists have isolated and extensively studied several of these components, seeking to understand their individual and synergistic contributions to the mushroom’s documented effects.
Research on Polysaccharide-K (PSK)
Polysaccharide-K, commonly known as PSK or Krestin, stands out as one of the most thoroughly researched compounds derived from turkey tail mushrooms. Originating from Japan, PSK has been the subject of numerous investigations for decades. Research on PSK predominantly focuses on its immune-modulating properties. Studies have explored its potential to influence various aspects of immune function, including its effects on cellular immunity and the production of specific immune mediators. This extensive body of scientific evidence has provided considerable insight into how PSK interacts with biological systems, making it a benchmark for understanding turkey tail’s potential.
Studies on Polysaccharide Peptide (PSP)
Another prominent bioactive compound identified in turkey tail mushrooms is Polysaccharide Peptide, or PSP. Primarily studied in China, PSP shares structural similarities with PSK but possesses distinct molecular characteristics and research profiles. Studies on PSP have also concentrated heavily on its immunomodulatory effects, exploring its capacity to support the immune system. Researchers have investigated PSP’s potential influence on various immune cell activities and its role in maintaining immune balance. Comparisons between PSK and PSP often highlight their unique contributions, underscoring the complexity and richness of the mushroom’s chemical composition.
Investigation of Other Bioactive Components
Beyond PSK and PSP, turkey tail mushrooms contain a spectrum of other bioactive components that are gaining increasing scientific attention. These include various types of polysaccharides, triterpenes, phenolic compounds, and antioxidants. Ongoing research aims to identify and characterize these lesser-known constituents and understand their individual and combined effects. Scientists are exploring how these components might work synergistically to contribute to the mushroom’s overall health properties, including its antioxidant and anti-inflammatory potential. The investigation into these diverse compounds highlights the holistic approach to understanding the full therapeutic scope of turkey tail mushrooms.
Interpreting Research Findings and Future Directions for Turkey Tail Studies

The ongoing scientific exploration of the turkey tail mushroom continues to yield valuable insights, yet it also presents challenges in interpretation and demands a forward-looking perspective. Accurately assessing the wealth of turkey tail mushroom research studies requires a nuanced understanding of their methodologies, limitations, and the dynamic nature of scientific discovery.
Understanding Study Limitations and Methodologies
When reviewing findings from turkey tail studies, it is crucial to consider the inherent limitations and diverse methodologies employed. Factors such as study design (e.g., *in vitro*, animal, or human trials), sample size, duration of intervention, and the specific extract used (e.g., fruiting body vs. mycelium, hot water vs. ethanol extraction) can significantly impact the results. Variability in the concentration of bioactive compounds across different preparations is also a critical consideration. Furthermore, the reliance on self-reported outcomes versus objective biomarkers, the potential for placebo effects, and the need for rigorous peer review are all vital aspects that researchers and consumers must acknowledge to interpret the scientific literature accurately.
Emerging Areas and Ongoing Research Efforts
The field of turkey tail research is dynamic, with scientists continuously exploring new avenues and refining existing understandings. Emerging areas of interest include the potential interplay between turkey tail compounds and the gut microbiome, which is increasingly recognized for its role in overall health and immunity. Researchers are also investigating personalized medicine approaches, exploring how individual genetic or metabolic profiles might influence responses to turkey tail supplementation. Ongoing research efforts are focused on conducting larger, multi-center clinical trials to provide more robust data, standardizing extraction methods, and identifying new applications for this versatile mushroom. These continuous investigations aim to further illuminate its complex mechanisms and expand our knowledge of its potential applications.
The journey from traditional wisdom to evidence-based science profoundly shapes our understanding of natural health agents like the turkey tail mushroom. Through meticulous research, the scientific community is steadily uncovering the complex array of bioactive compounds and their potential effects on human health, particularly concerning immune modulation. While significant progress has been made, the continuous pursuit of knowledge through rigorous research methodologies remains essential. This dedication to scientific inquiry ensures a more complete and accurate comprehension of the turkey tail mushroom’s role in supporting health and well-being.
The information in this article is intended for knowledge purposes only. It is not a substitute for professional medical advice, diagnosis, or treatment. Always seek the advice of a qualified healthcare provider for any questions regarding a medical condition or before making any decisions related to your health or treatment.
FAQ
— What does current research say about turkey tail mushrooms and immunity?
Current research indicates that turkey tail mushrooms have been extensively studied for their potential to support various aspects of the immune system. These investigations often explore how the mushroom may help maintain immune balance and responsiveness within the body.
— Are there specific clinical trials on turkey tail mushrooms for immune health?
Yes, there have been a number of human clinical investigations into turkey tail mushrooms, particularly exploring their role as a complementary support for immune health in various populations. Much of the turkey tail mushroom research studies have focused on understanding its mechanisms in real-world scenarios.
— How do scientists explain turkey tail mushroom’s immune-modulating effects?
Scientists explain turkey tail’s immune-modulating effects by highlighting its ability to influence the communication pathways among immune cells. It is thought to help the immune system adapt and respond appropriately to various challenges, rather than simply “boosting” it. This modulation is key to maintaining overall immune balance.
— Which active compounds in turkey tail are most studied for immune benefits?
The most extensively studied active compounds in turkey tail for immune benefits are polysaccharide-K (PSK) and polysaccharide-peptide (PSP). These unique beta-glucans are known for their ability to interact with and support the function of various immune cells, such as macrophages and natural killer cells.
— What is the scientific evidence for turkey tail mushrooms’ health properties?
Scientific evidence for turkey tail mushrooms’ health properties largely centers on its documented impact on immune function. Beyond immunity, there is also research exploring its potential relevance to gut health and its antioxidant properties. The mushroom’s diverse biological activity continues to be an area of active investigation.